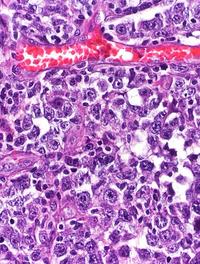

Prendre le train du sommeil avec la thérapie de restriction dispensée par une infirmière

La thérapie cognitivo-comportementale (TCC) est recommandée comme traitement de première intention de l'insomnie, mais l'accès à la [...]

La thérapie cognitivo-comportementale (TCC) est recommandée comme traitement de première intention de l'insomnie, mais l'accès à la [...]

Le cancer appendiculaire à cellules caliciformes (KCC) est une entité rare de tumeur endocrine composée de cellules sécrétoires notamment [...]

L’hyperéosinophilie relève de causes multiples et les pathologies sous-jacentes sont le plus souvent bénignes, mais il est des cas [...]

L'insuline BIF (Basal Insulin Fc, ou LY3209590) en prise unique hebdomadaire s'est montrée sûre et non inférieure à l'insuline de référence [...]

La stéatopathie métabolique (NASH) manque cruellement de traitements efficaces sur les aspects métaboliques, inflammatoires et fibrosants. [...]

Il a été signalé récemment que les jeux électroniques pouvaient provoquer, chez certains sujets sensibles, des troubles du rythme cardiaque [...]

L’Indian Journal of Psychiatry consacre un article à un sujet fréquent et très préoccupant, dans la pratique médicale : la non-observance [...]

La carcinose péritonéale est une complication grave propre à certains cancers de la cavité abdominopelvienne, notamment ceux de l’ovaire, [...]

Cette étude britannique réalisée chez 35 enfants présentant une épilepsie réfractaire au traitement médicamenteux montre qu’une association [...]

Le papillomavirus humain (HPV) est le virus à transmission sexuelle le plus couramment retrouvé dans des lésions à fort potentiel malin. [...]

Cette première chez l’homme avait pour but de tester, lors d’un TAVI (transcatheter aortic valve implantation) la sureté d’emploi et [...]
Le lymphome diffus à grandes cellules B (LDGCB) est le type le plus courant de lymphome non hodgkinien. Le traitement standard de première [...]

Aux Etats-Unis, on estime actuellement à 1,2 millions le nombre de personnes porteuses du VIH (prévalence globale 0,3 %), et à plus [...]

L’activité physique d’intensité modérée à vigoureuse (APMV) réduit le risque de mortalité toutes causes confondues, par maladies cardiovasculaires [...]

Les anticorps monoclonaux inhibiteurs de l'interleukine 12/23 (IL-12/23) ou de l’interleukine 23 (IL-23) seraient plus efficaces que [...]

Voisin du concept philosophique d’énandiodromie (le retournement des choses en leur contraire, comme par exemple dans le proverbe « [...]

La prise en charge des cancers gynécologiques a connu des changements importants en quelques années, grâce à l’intégration en pratique [...]

Un taux plasmatique trop élevé de LDL-cholestérol (LDL-c) constitue un facteur de risque majeur de maladie cardiovasculaire (MCV) et [...]

Plusieurs études ont rapporté une hausse de l’incidence des diabètes de type 1 (T1D) et 2 (T2D) durant la pandémie de Covid-19 chez [...]

L’insuffisance rénale chronique (IRC) représente un enjeu majeur de santé publique et ceci risque de s’accroitre d’ici 2030 puisqu’il [...]

L’adénocarcinome canalaire pancréatique (ACP) représente la forme la plus fréquente des tumeurs malignes du pancréas (plus de 90 % [...]

Dans le traitement des méningites à Listeria monocytogenes, les recommandations actuelles prônent l’arrêt de la dexaméthasone quand [...]

Les anomalies du tube neural sont parmi les malformations congénitales les plus fréquentes aux Etats-Unis, affectant environ 3 000 [...]

L’obésité pèse de plus en plus lourdement sur les systèmes de santé dans la plupart des pays. Elle toucherait plus d’un milliard d’individus [...]

Certains patients souffrant d’un reflux gastro-œsophagien (RGO) sont réfractaires au traitement par inhibiteurs de la pompe à protons [...]

Parfois très subtile, la distinction conceptuelle entre une association et une relation de causalité s’appuie sur les critères de Hill[1], [...]

La prise en charge des patients atteints d’un cancer du poumon non à petites cellules (CPNPC) sans altération génétique actionnable [...]

Alors que les effets de l'infection par le SARS-CoV2 sur l'évolution des maladies hématologiques ont été bien documentés, peu de données [...]

L’étude Global Burden of Diseases, Injuries, and Risk Factors Study (GBD) quantifie systématiquement les répercussions sur la santé [...]

Les accidents ischémiques transitoires (AIT) sont en général le prélude aux accidents vasculaires cérébraux (AVC) ischémiques. Cette [...]